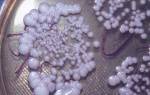

Для профилактики и терапии развития воспалительных процессов, половых инфекций назначается препарат Вагилак (Vagilac). Он выпускается в разных формах, укрепляет иммунитет, нормализует гормональный фон. Медикамент включает несколько видов полезных бактерий Lactobacillus rhamnosus, которые помогают восстановить микрофлору органов.
Состав Вагилака
Лекарство выпускается в разных формах. Информация по составу указана в инструкции по применению:
|
Капсулы вагинальные |
Капсулы |
Гель |
|
|
Форма выпуска |
Полимерные флаконы (по 10 штук белого цвета). |
Из желатина с порошком внутри (одна пластинка – 15 штук в картонной упаковке). |
Прозрачная бесцветная жидкость (туба 50 г). |
|
Бактерии |
Lactobacillus delbrueckii subsp. Bulgaricus, Lactobacillus rhcunnosus, Streptococcus thermophilus, Lactobacillus acidophilus. |
Пробиотические штаммы лактобактерий Lactobacillus rhamnosus GR-1, Lactobacillus reuteri RC-14. |
Lactobacillus reuteri, Lactobacillus rhamnosus. |
|
Остальные компоненты |
Аскорбиновая кислота, лактоза. |
Крахмал, декстроза, желатин, микрокристаллическая целлюлоза, магния стеарат, диоксид титана. |
Сорбат калия, молочная кислота, гидроксиэтилцеллюлоза, очищенная вода, пропиленгликоль. |
Мнение врача:
Вагилак – это препарат, который часто назначается врачами для лечения дисбактериоза и других нарушений микрофлоры кишечника. Его основным действующим веществом является лактобактерии. Препарат выпускается в форме капсул, порошка и сиропа, что делает его удобным для применения как взрослыми, так и детьми. Врачи рекомендуют Вагилак при нарушениях пищеварения, диарее, после приема антибиотиков, а также для профилактики дисбактериоза. Дозировка и цена препарата зависят от его формы выпуска и производителя, поэтому перед применением следует проконсультироваться с врачом.

Фармакологические свойства
Любая лекарственная форма противоинфекционного препарата способствует регенерации нормальной микрофлоры, восстановлению уровня кислотности половых женских путей. Основные фармакологические функции:
- Пероральные капсулы Вагилаквпитываются в ткани органов через кишечник. Состав таблеток включает несколько видов лактобацилл, которые взяты не из кишечной флоры, а из урогенитальных путей здорового человека. Препарат попадает во влагалищную среду, населяя ее полезными бактериями. Они помогают уничтожить инфекцию. Вещества, которые содержатся в капсулах, сводят к минимуму повторное появление заболеваний и предупреждает их первоначальное развитие.
- Удобные вагинальные капсулы Вагилакдля введения во влагалище приводят в норму микрофлору, снижают риск появления вагиноза, блокируют развитие вредоносных микроорганизмов.
- Гельхорошо увлажняет слизистую оболочку вагины, значительно повышая качество сексуальной жизни. Составные элементы жидкого лекарства восполняют недостаток естественной смазки, убирают жжение, зуд, микротрещины. Медикамент активно всасывается в ткани, не оставляет следов на одежде и коже.

Нормальная микрофлора влагалища женщины содержит лактобактерии, которые защищают организм от попадания инфекции внутрь. Полезные бактерии связываются с клетками эпителия и продуктами антимикробных соединений, что помогает контролировать вагинальный микробиоценоз (совокупность разных микроорганизмов). Лактобактерии относят к грамположительным организмам, факультативным анаэробным образованиям. У них нет спор, но они могут повлиять на процедуру распада углеводов и образование молочной кислоты, которая замедляет рост патогенов.
Интересные факты
-
Вагилак – это новый пробиотик, содержащий комбинацию штаммов лактобактерий, которые поддерживают здоровье влагалища и оказывают положительное влияние на иммунную систему. Он помогает восстановить баланс микрофлоры влагалища и предотвращает развитие инфекций.
-
Вагилак выпускается в форме вагинальных капсул, что обеспечивает быстрое и эффективное действие препарата. Капсулы вводятся непосредственно во влагалище, где они растворяются, высвобождая активные вещества.
-
Вагилак показан при различных нарушениях микрофлоры влагалища, включая бактериальный вагиноз, кандидозный вульвовагинит, неспецифический вагинит и другие инфекции влагалища. Он также может использоваться для профилактики инфекций влагалища у женщин с ослабленным иммунитетом или после курса антибиотиков.

Показания к применению
Инструкция по применению Вагилака включает список показаний. Средство используют при таких состояниях и заболеваниях:
- Терапия антибиотиками, противовирусными и противогрибковыми медикаментами, кортикостероидами, цитостатиками, период после нее.
- Применение контрацептивов: внутриматочная спираль, спермициды, комбинированные оральные противозачаточные.
- Дисбиоз (нарушение нормальной микрофлоры) влагалища, включая бактериальный вагиноз. Используется в качестве самостоятельного препарата или при комплексном лечении.
- Подготовка перед родовой деятельностью, диагностикой заболевания, плановой гинекологической операцией.
- Вагилак нередко применяют как самостоятельный медикамент или для специфического гормонального лечения, направленного на устранение гормонозависимого кольпита (воспалительный процесс влагалищной слизистой оболочки).
- Устранение сухости, дискомфорта при наступлении менопаузы, во время стрессов, физического и эмоционального переутомления.
- Антимикробная, иммуномодулирующая, противовирусная терапия урогенитальных заболеваний и патологий, которые передаются половым путем (хламидиоз, гонорея, трихомониаз, герпес генитальный и т.д.).
- Хроническая и подострая формы воспаления женских половых органов.
Опыт других людей
Вагилак – это эффективное средство для улучшения пищеварения и поддержания здоровой микрофлоры кишечника. Пользователи отмечают удобство применения благодаря инструкции по применению, которая подробно описывает режим и дозировку. Состав включает полезные микроорганизмы, которые способствуют нормализации работы ЖКТ. Препарат доступен в удобной форме выпуска, что также получило положительные отзывы. Люди отмечают эффективность Вагилака при различных пищеварительных расстройствах. Цена доступна и оправдывает качество продукта. Вагилак – надежное средство для поддержания здоровья ЖКТ.
Способ применения и дозировка
Длительность лечения, дозировка и режим применения назначается в зависимости от лекарственной формы, конкретной болезни. По инструкции капсулы принимают внутрь, вагинальную разновидность используют интравагинально, гель наносят на наружные половые органы или смазывают влагалище перед половым актом. Перед началом терапии нужно обязательно проконсультироваться с врачом.
Капсулы Вагилак
Согласно инструкции по применению эта разновидность Вагилака принимается внутрь, ее запивают небольшим количеством воды. Чтобы полностью восстановить нормальную микрофлору требуется употреблять по 1 капсуле в сутки. Курс лечения составляет от 2 до 6 недель. Когда препарат используется одновременно с антибиотиками для терапии воспалений, то нужно пить по 2 в день (с промежутком между приемами в два часа).
После завершения лечения антибактериальными медикаментами, Вагилак назначают для профилактики по 1 штуке за сутки в течение 14-21 дней. Чтобы избежать появления дисбактериоза из-за применения противозачаточных средств, капсулы принимают по 1 шт. в сутки. Курс лечения 20-28 дней. Перед родами и гинекологическими операциями назначают по одной за день курсом 14 суток.
Статьи по теме
- Гайро – инструкция по применению препарата
- Гексализ – инструкция по применению, механизм действия, противопоказания и аналоги
- Рабелок – инструкция по применению и аналоги
Вагинальные капсулы
Вагинальные капсулы Вагилак вводят перед сном как можно глубже. Ставят по одной в сутки при наличии воспалительных инфекционных болезней. По инструкции вагинальные капсулы применяют на 5 день после начала терапии антибиотиками. Курс лечения длится 10 дней. В целях защиты от развития нарушений влагалищной микрофлоры вводят по 1 штуке каждый день (на протяжении 2-ой половины цикла менструации).
Гель Вагилак
Данная форма препарата по инструкции применяется местно. Гель в небольшом количестве наносят на чистые пальцы, а потом смазывают наружные половые органы. Чтобы ввести средство во влагалище применяется специальный аппликатор. Сначала его наполняют гелем, приложив вплотную к отверстию тубы и слегка нажав на нее. Затем приспособление вводят глубоко в половые пути и выдавливают. Многоразовый аппликатор надо хорошо вымыть, высушить салфеткой и убрать в упаковку до следующего применения.

Особые указания
Если лекарство с лактобактериями применяют для избавления от молочницы, то оно эффективно устраняет зуд, болевые острые ощущения, восстанавливает микрофлору влагалища. При терапии кандидоза врач может назначить целый комплекс, в который входят все формы препарата. Применение средства Вагилак не влияет на концентрацию внимания, скорость психомоторной реакции человека. Нельзя употреблять лекарство с алкоголем, так как спиртное уничтожает полезные организмы и усугубляет заболевание.
Вагилак при беременности
В период вынашивания ребенка женщине можно применять любую форму средства для профилактики развития дисбактериоза. Специалисты советуют принимать пероральные капсулы (по 1-ой в сутки) с 10 по 12, 20 по 22 и 36 по 38 неделю беременности. Если будущая мама принимала антибиотик, то Вагилак назначают месячным курсом по 1 штуке за день. За 2 недели до ПДР гинеколог может выписать капсулы (по 1 в сутки) или введение геля в самом начале процесса схваток.
Лекарственное взаимодействие
Нередко комбинируют с антимикробными лекарственными средствами для курса терапии против вагиноза.
Медикамент принимают вместе с антибиотиками широкой области действия, противогрибковыми препаратами, сульфаниламидами.
С каким лекарством совмещать Вагилак, зависит от возбудителя патологии.
Побочные действия
Медикамент Вагилак, как правило, не вызывает побочных эффектов, изменения наблюдаются в редких случаях. При использовании таблеток, свечей и/или геля отмечается гиперемия влагалищной слизистой, жжение, дискомфорт, вызванные аллергией на составные компоненты лекарства.
Противопоказания
По инструкции любую форму медикаментозного средства нельзя применять при наличии ряда состояний или заболеваний. Противопоказания:
- гиперчувствительность (непереносимость) к составу лекарства;
- острые виды воспалений во влагалище;
- эрозивные очаги в половых путях.
Условия продажи и хранения
Капсулы и гель можно купить без рецепта. По инструкции хранят препарат в недоступном для детей месте, при температуре не больше +25 градусов. Срок годности составляет два года.
Аналоги
Сегодня не существует прямых аналогов медикамента. Он считается уникальным по составу. Лекарство можно заменить средствами с похожим терапевтическим эффектом. Популярные аналоги Вагилака:
- БАД (биологически активная добавка) Пролит. Ее добавляют в пищу, для обогащения организма калием, органическими кислотами, дубильными веществами. Пролит улучшает работу мочеполовой системы, оказывает положительное влияние на обмен веществ при мочекаменной болезни.
- Суппозитории, таблетки Ацилактпо инструкции применяют для терапии вагинального дисбактериоза, неспецифических воспалений во влагалище.
- Порошок, ампулы, свечи и капсулы Лактобактеринпомогают восстановить нормальную кишечную микрофлору. Препарат повышает иммунитет, уничтожает вредоносные бактерии.
- Порошок и таблетки Бифидумбактеринпредназначены для терапии патологий ЖКТ (желудочно-кишечного тракта), нарушения чистоты секреции влагалища при беременности, гормональных и сенильных кольпитов.
- Средство в капсулах Бактериобалансвключает лактобактерии/бифидобактерии, которые проникают в кишечник и защищают организм от действия антибиотиков, препаратов для химиотерапии.
- Препарат Бифи Нормолайзертакже относится к БАДам. Он содержит бифидобактерии, которые нормализуют иммунную функцию, восстанавливают метаболизм, защищают организм от вирусов, бактерий.

Цена Вагилака
Медикаментозное средство можно приобрести в любом аптечном киоске Москвы и области. Дешевле и удобнее заказать лекарство в интернет-аптеке по каталогу. Его стоимость будет зависеть от формы и места реализации. Примерная цена Вагилака:
|
Форма |
Аптека |
Стоимость (в рублях) |
|
Гель вагинальный (50 мл) |
Аптека.ру |
350-400 |
|
Капсулы пероральные (15 шт.) |
Пилюли. ру |
600-650 |
|
Гель для интимной гигиены |
Лаборатория Красоты и Здоровья |
380-400 |
|
Капсулы(№15) |
Диалог |
550-590 |
|
Вагинальные суппозитории (10 шт.) |
Унифарм |
500-600 |
Видео
Внимание!
Информация, представленная в статье, носит ознакомительный характер. Материалы статьи не призывают к самостоятельному лечению. Только квалифицированный врач может поставить диагноз и дать рекомендации по лечению, исходя из индивидуальных особенностей конкретного пациента.
Частые вопросы
Какие показания для применения препарата Вагилак?
Препарат Вагилак применяется при нарушениях микрофлоры влагалища, в том числе при вагинозе и вагинальных инфекциях.
Какова дозировка и способ применения препарата Вагилак?
Дозировка и способ применения препарата Вагилак зависят от формы выпуска и характера заболевания. Обычно препарат вводится влагалищно в соответствии с инструкцией.
Какова цена и форма выпуска препарата Вагилак?
Препарат Вагилак выпускается в виде влагалищных капсул и крема. Цена может варьироваться в зависимости от аптеки и региона, но обычно она доступна и не является высокой.
Полезные советы
СОВЕТ №1
Перед началом применения препарата Вагилак обязательно проконсультируйтесь с врачом или фармацевтом, чтобы получить рекомендации по дозировке и противопоказаниям.
СОВЕТ №2
Внимательно изучите инструкцию по применению Вагилака, чтобы правильно использовать препарат и избежать возможных побочных эффектов.
СОВЕТ №3
Не превышайте рекомендуемую дозировку Вагилака и не применяйте его длительное время без назначения врача.